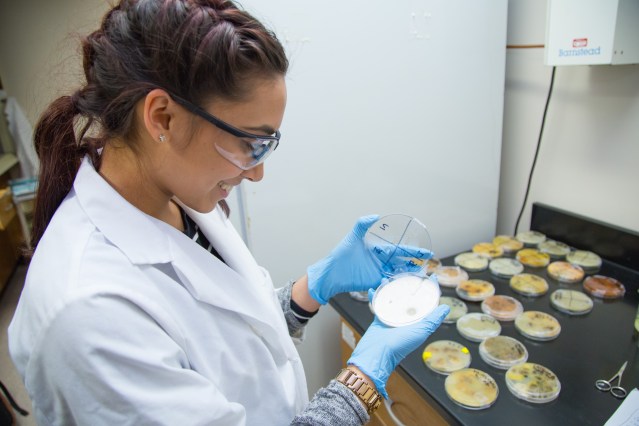

Eight of Brookdale’s highest achieving science, technology, engineering and mathematics (STEM) students have spent the year working with local experts on a variety of year-long research initiatives as part of an ongoing grant program funded by NASA and the New Jersey Space Grant Consortium (NJSGC).
The NASA STEM Fellows, who also serve as peer tutors in the Brookdale’s STEM Institute, received a $5,000 fellowship toward their education and presented the final results of their work earlier this month.
Sameerah Wahab, a biology major and NASA STEM Fellow at Brookdale Community College in Monmouth County, inspects a variety of fungus as part of a year-long research project. Photo by Brookdale Community College.
“This has been a wonderful opportunity for everyone involved,” said assistant biology professor Gitanjali Kundu, who co-administers the grant program at Brookdale with assistant mathematics professor Susan Monroe. “It gives the students wonderful exposure to different kinds of research work and opportunities outside of Brookdale in terms of collaboration.
“Other Brookdale students also benefit from the free tutoring that each STEM Fellow provides. They are there for their fellow students, and they can serve as role models for students who may just be starting out in a major or a career path.”
Throughout this year each STEM Fellow worked with dedicated mentors from a local college, university or the private sector on a real-world research initiative in their field of study.
The projects included a music-oriented challenge by electrical engineering major Joe Bongiorno, who combined his lifelong passions for music and electronics by working to create new digital effects for the electric base guitar. He also aimed to break down the instrument’s circuitry in an effort to show how digital effects can be created and manipulated to create new, unique sound profiles.
“I couldn’t be more grateful for this opportunity,” said Bongiorno. “I work outside of school, but I say all the time that college is my real job. Because this is what I love. The fellowship is a huge plus, don’t get me wrong, but this wasn’t about the money for me. This was about the experience. For an undergrad, something like this is awesome.”
Second-year biology major Grace Groh worked with an orthopedic surgeon to study a new method of ACL reconstruction surgery which uses dissolvable plastic screws instead of metal ones. An aspiring health care professional, Groh said she hoped to assist in tracking the results of the new method, which is believed to be more efficient and allows patients to recover quicker.
Former Brookdale Automotive Technology graduate Anthony Mauro pursued his new passion for mechanical engineering by working with an automotive professor to restore and reinvigorate an old hybrid car. Throughout the year Mauro worked to repair the car’s aging battery cells and improve its gas mileage and performance, in an attempt to bring it in line with models that are being produced today.
“It’s a big workload, but it’s what I’m good at,” said Mauro, a husband and young father working toward a new career in automotive engineering. “As a full-time student with a family, this fellowship is a huge opportunity for me.”
Andrea Sissick, a second-year environmental science major, spent the year studying marine life, ocean acidification and climate change impacts off the coast of Sandy Hook with two Rutgers professors. Specifically, Sissick helped study three species of fish that have moved away from their traditional habitats in an effort to understand their new environmental needs and future migration patterns.
And second-year biology major Sameerah Wahab will work with a local botany professor to study and attempt to eliminate an invasive species of fungus that is currently decimating area vineyards.
A member of the Brookdale chapter of Phi Theta Kappa International Honor Society and one of the top 20 community college students in the country in 2015, Wahab said she was grateful for the opportunity to advance her education while giving back to her fellow students.
“I’m extremely happy to have been selected for this program,” said Wahab. “As a returning student, I feel that you have a responsibility to reach out to newer students and help them conquer the same obstacles you went through. At a community college, that’s what we’re supposed to be doing – acting as a community.”
Categories: Public 2-Year Schools
As 2017 draws to a close, it is time for us to reflect on the progress we have made and the challenges ahead of us. A few weeks ago, my office hosted an event entitled, “65 by ’25… Many Paths, One Future: The Equity Imperative,” at the Educational Testing Service (ETS) in Princeton. We heard an enlightening address from Dr. Michael T. Nettles, ETS senior vice president for research, and recognized four New Jersey programs for excellence and equity in education.





